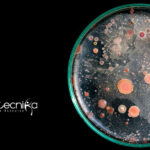
NIT Rourkela MSc

Home Search
microbiology - search results
If you're not happy with the results, please do another search
Biotecnika Times – Newsletter 19.07.2021 – INSA Recruitment, Schrödinger Workshop, CSIR
Biotecnika Times - INSA Recruitment, Schrödinger Workshop, CSIR
Indian National Science Academy (INSA) Project Associate Recruitment
Indian National Science Academy (INSA) Project Associate Recruitment. Project Associate...
Amity Institute of Biotechnology Project Assistant-1 /JRF Job
Amity Institute of Biotechnology Project Assistant-1 /JRF Job
Amity Institute of Biotechnology Project Assistant-1 /JRF Job. Amity Institute of Biotechnology, Amity University, Noida Vacancy. Amity...
Toppers Strategy For CSIR-NET Life Sciences Preparation – Breakdown of Important Units
CSIR-NET Life Sciences Preparation - A Unit-wise Strategy
The CSIR-NET exam is among the most coveted competitive exams in India. Therefore, its importance and precedence...
Biotecnika Times – Newsletter 16.07.2021 – Govt DST Food Technologist Recruitment, Govt CNCI
Biotecnika Times - Govt DST Food Technologist Recruitment, Govt CNCI
DST GoI Food Technologist Recruitment at NECTAR – Applications Invited
Govt Food Technologist Job Opening –...
NIAB MSc & MTech Junior Research Fellow Job – Life Sciences Apply
NIAB JRF Vacancy For MSc & MTech Life Science
NIAB JRF Vacancy For MSc & MTech Life Science. National Institute of Animal Biotechnology (NIAB) is...
CSIR-CIMAP Project Associate Recruitment – Online Application Process
CSIR-CIMAP Project Associate Recruitment - Online Application Process
CSIR-CIMAP Project Associate Recruitment - Online Application Process. Government jobs for MSc in Life Sciences/Microbiology/Botany candidates. Interested...
Genome Sequencing of the SARS-CoV2 Variants Project Recruitment at CSIR-IICB
CSIR-IICB SARS-CoV2 Project Associate Jobs - Apply Online
CSIR-IICB SARS-CoV2 Project Associate Jobs - Apply Online. MSc Biological / Life Science / Microbiology / Biochem...
NIT Rourkela MSc & MTech Life Sciences Research Fellow Job
NIT Rourkela MSc & MTech Life Sciences Research Fellow Job
NIT Rourkela MSc & MTech Life Sciences Research Fellow Job. Life Science/ Microbiology/ Biochemistry/ Biotechnology/...
Biotecnika Times – Newsletter 13.07.202 – IIT JAM 2022 & BARC OCES-2021 Notification
Biotecnika Times - IIT JAM 2022 & BARC OCES-2021 Notification
IIT JAM 2022 Official Notification – Eligibility, Dates, Application Process, Deadline
IIT JAM 2022 Notification...
Bharathidasan University Biological Sciences Project Fellow Job
Bharathidasan University Biological Sciences Project Fellow Job
Bharathidasan University Biological Sciences Project Fellow Job. MSc jobs at Bharathidasan University. Project Fellow jobs for MSc Zoology/...
BARC OCES-2021 and DGFS-2021 Notification – DAE-Training Schools Scientific Officers Recruitment 2021
BARC OCES-2021 and DGFS-2021 Notification - DAE-Training Schools Scientific Officers
BARC OCES-2021 and DGFS-2021 Notification - DAE-Training Schools Scientific Officers. DAE-BARC raining Schools Scientific Officers...
BHU Junior Research Assistant Job Opening Available
BHU Research Assistant Recruitment - Applications Invited
BHU Research Assistant Recruitment - Applications Invited. BHU, Varanasi is hiring for a research position. MSc Biochemistry/ Biotechnology/...
CSIR-IICB Corona Sample Testing Project Recruitment – Apply Online
CSIR-IICB Project Associate Jobs - Online Applications Invited
CSIR-IICB Project Associate Jobs - Online Applications Invited. MSc Biological / Life Science / Microbiology / Biochem...
Biotecnika Times – Newsletter 12.07.2021 – CDFD Genomics Vacancy, Shell India Scientist
Biotecnika Times - CDFD Genomics Vacancy, Shell India Scientist
COVID-19 Genetic Epidemiology of SARS CoV2 in India Project Recruitment at CSIR-IGIB
CSIR-IGIB Jobs Biological Sciences –...
Student Internship at PGIMER – Applications Invited
Student Internship at PGIMER - Applications Invited
Student Internship at PGIMER - Applications Invited. Student Internship jobs at PGIMER. PGIMER is Hiring MSc candidates for...